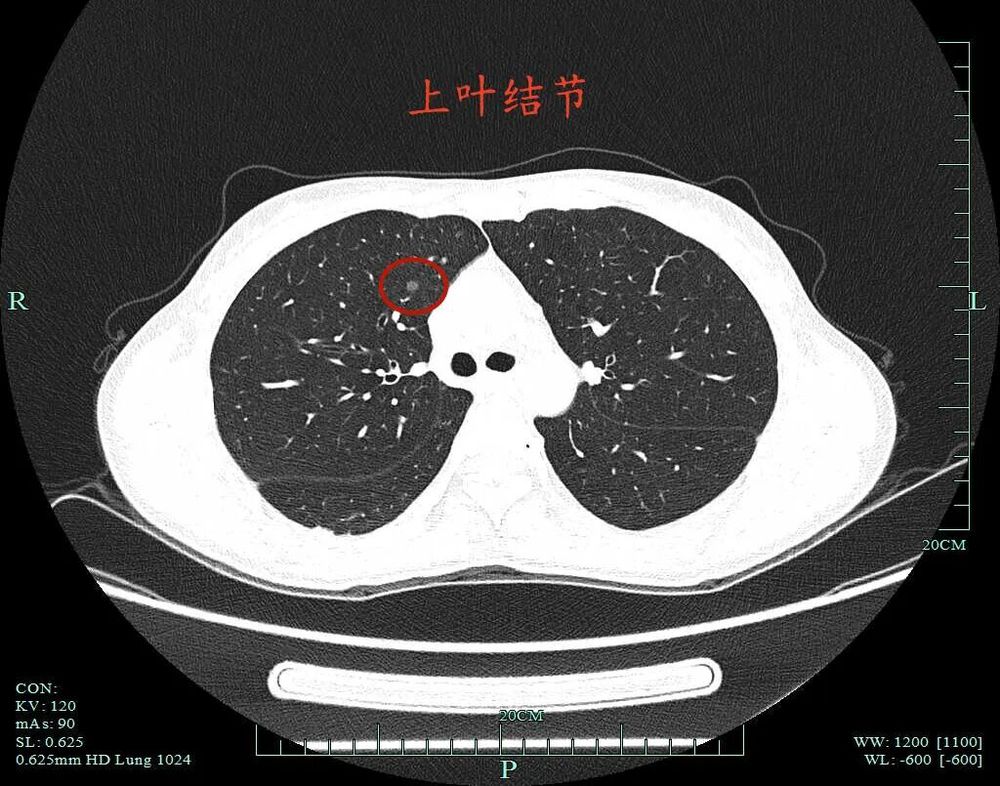
图片
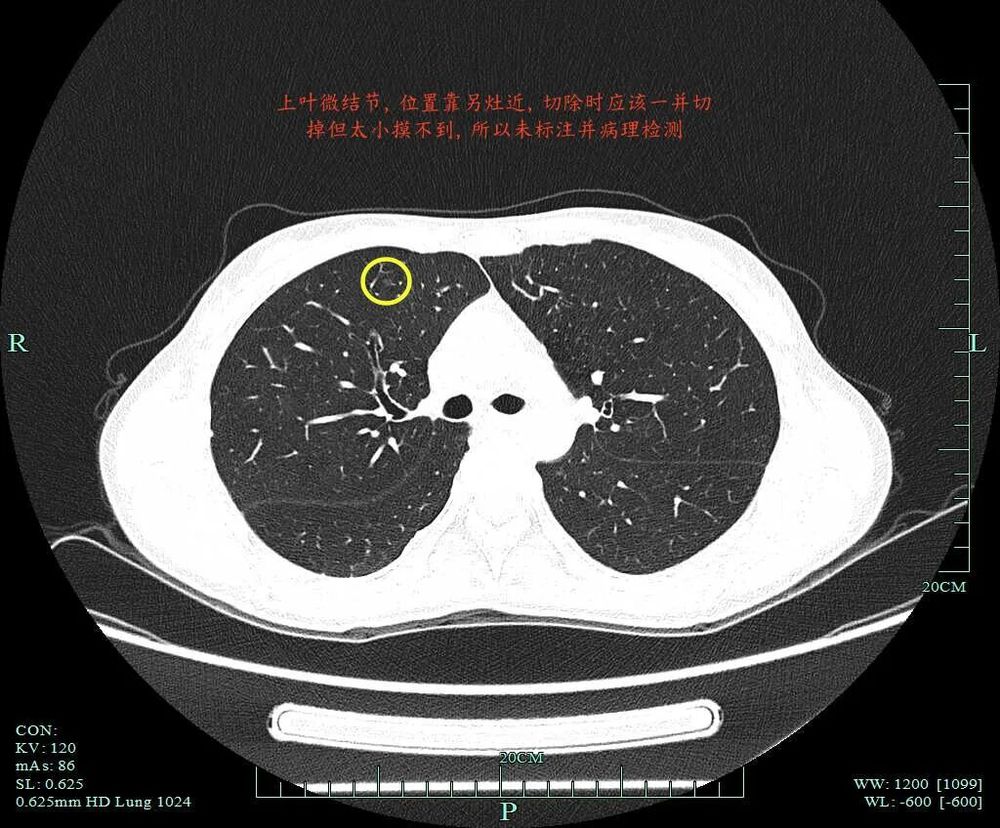
图片

右肺有4处结节,为何手术时留了1处在里面?
2026年4月21日
前言:肺多发结节考虑是多原发早期肺癌时,指南的意见是怎样的呢?指南上说优先处理主病灶,兼顾次病灶,在不影响生存及符合无瘤原则前提下尽量切除病灶并尽可能保留肺功能。次病灶若是纯GGO,受限于心肺功能无法全部切除时,建议6-12个月随访1次。也就是说:如果心肺功能吃得消,即便次病灶是纯GGO,也是应该尽量切除。这个原则也是宣扬“一网打尽”处理肺结节的医生的指导性原则。但我总觉得指南也是人定的、脱胎于临床研究与回顾分析得出的结论肯定会落后于疾病的发展与时代的变化、疾病谱的改变,从而不一定适应临床。死守指南会导致患者肺功能受损明显、创伤太大、费用过高,而且无法解决导致多发病灶的机体内环境与外环境因素,从而难以避免后续随访中再检出新的病灶。所以我一直宣扬“抓大放小”。今天分享的这个病例右侧较为明显的有四处病灶,主病灶A在右下叶靠近叶间裂,次病灶一处在右上叶病灶B,一处在右下病灶C,还有一处密度很淡的病灶D是邻近病灶B的。我们是如何决策与考虑的?
患者,女性,45岁,检查发现肺部结节入院,临床没有症状,肿瘤指标没有异常。非薄层上右下主病灶A有微小血管进入,距离胸膜近,表面不平,灶内密度稍不均。薄层上病灶出现,靠叶间裂处密度高呈实性成分,边上是磨玻璃成分,轮廓较清。病灶处叶间裂密度较高,灶内有条状偏高密度,磨玻璃成分较淡。灶内密度欠均匀,紧贴叶间裂,部分边缘略毛糙,整体轮廓清楚。灶内偏实性成分明显,但不是太高的密度,贴胸膜近,略有牵拉,浅分叶明显,整体轮廓与瘤肺边界清。小血管进入以及灶内小部分密度偏高,与叶间裂没有间隙,是紧贴的。灶内密度不均,叶间裂处增厚与密度增高,血管进入,表面不平以及细毛刺可见。病灶混合密度,实性成分有收缩力与纠集感,磨玻璃部分密度较低,表面不平,细毛刺可见,紧贴叶间裂。下叶病灶C也是磨玻璃密度,但位置较深,在前基底段与内基底段交界附近,考虑不典型增生或原位癌可能性大,尤其是前者。病灶A是主病灶,且由于混合密度以及实性成分紧贴叶间裂,又有血管进入以及浅分叶征,表面不平毛糙,高度怀疑是浸润性腺癌的,随访有风险,宜干预处理;病灶B密度淡而纯,也不大,但右侧已经手术要处理病灶A的话,此灶由于也靠右上叶胸膜不太远,在纵隔侧,可以考虑定位后局部楔形切除,切除时病灶D应该由于位置邻近能一并切除,但太小太淡,在标本上估计无法扪及;病灶C虽也考虑是恶性范畴的,但若手术得切除下叶前内基底段,加上病灶A已经切除部分下叶,还要切除病灶B,我觉得创伤较大,而患者年经仍轻,关键的是目前明显的有四处,后续随访中大概率会再检出新的,过大的创伤换取危险性并不大的病灶切除,利弊权衡感觉不划算。若病灶C先随访留待后续有变化并风险增加时再处理,一是或许要好几年;二是可能届时肺结节诊疗的观念理念及技术可能会变;三是就算几年后仍与目前理念一样,而此灶风险增加,再做肺段切除并不是不可以。所以我们倾向先楔形切除风险最大的病灶A,顺带处理也较为边上的病灶B以及邻近的病灶D,病灶C先随访。经过充分沟通以及结友与家人商量后,同意采纲我们的意见,遂办理入院地手术,由杭州市第一人民医院胸外科叶建明团队为其进行了手术。病理报告示:右下主病灶微浸润性腺癌,长径1.3厘米,未侵犯胸膜;上叶病灶是原位癌,长径0.6厘米。切缘均阴性。右下病灶C于2026年1月份复查时仍与2023年4月术前时几乎没有变化,考虑腺体前驱病变,仍可再随访。多发结节的处理没有完全统一的标准,指南的意见也是原则性的,而且我总觉得不适应磨玻璃肺癌的诊疗现状,如果按指南办,容易过度治疗。主要是磨玻璃肺癌与传统实性肺癌不同的生物学特征导致的。基于风险高低并结合患者年纪、病灶个数与部位、结节密度与随访进展情况评估、患者意愿以及可选择的手术方式不同带来的创伤大小与对后续再发结节处理是否留有余地等因素都得考虑,并综合权衡利弊,在充分知情同意的情况下,抓大放小的原则来处理或许才是更为合理的。因为医学会发展,对疾病的认知会更新,而指南却总是滞后于临床的!